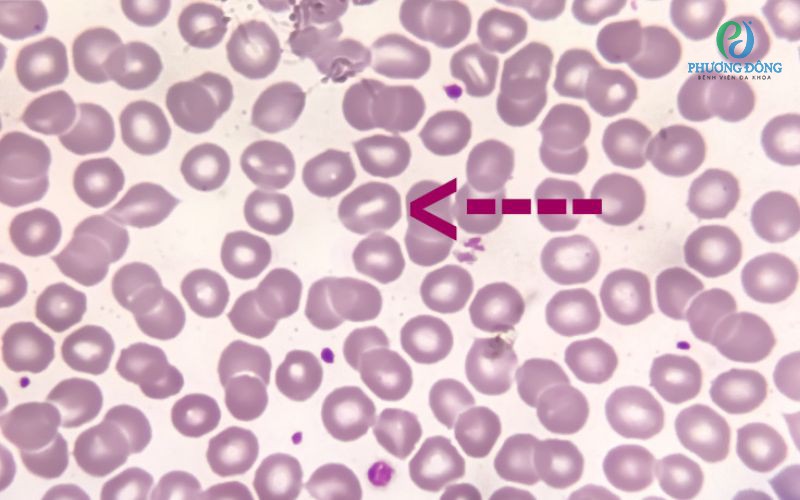

Hồng cầu hình cầu là gì?
Trong điều kiện bình thường, hồng cầu có dạng đĩa lõm hai mặt, giúp chúng dễ dàng di chuyển trong hệ thống mạch máu và vận chuyển oxy đến các mô.
Hồng cầu hình cầu là những tế bào hồng cầu đã mất đi hình dạng đĩa đặc trưng và trở thành dạng tròn hoặc gần giống hình cầu. Sự thay đổi hình thái này xảy ra do các bất thường ở protein màng tế bào, khiến cấu trúc khung nâng đỡ của hồng cầu bị suy giảm.
Một số protein quan trọng có thể bị thiếu hụt hoặc bất thường gồm: Ankyrin, spectrin, band, band 4.2. Các protein này được mã hóa bởi những gen khác nhau và có vai trò duy trì sự ổn định của màng hồng cầu. Khi các protein này bị đột biến, hồng cầu trở nên kém linh hoạt, dễ bị phá hủy khi lưu thông trong cơ thể.
 Hồng cầu hình cầu là tình trạng tế bào hồng cầu mất hình dạng đĩa đặc trưng
Hồng cầu hình cầu là tình trạng tế bào hồng cầu mất hình dạng đĩa đặc trưng
Bệnh hồng cầu hình cầu di truyền là gì?
Bệnh hồng cầu hình cầu di truyền là một rối loạn di truyền gây ra thiếu máu tan máu. Trong tình trạng này, các hồng cầu bất thường bị phá hủy sớm hơn so với vòng đời bình thường của hồng cầu.
Ở người khỏe mạnh, hồng cầu có tuổi thọ trung bình khoảng 120 ngày. Tuy nhiên, ở người mắc bệnh hồng cầu hình cầu, hồng cầu có thể bị phá hủy chỉ sau vài ngày hoặc vài tuần.
Đây được xem là một trong những nguyên nhân phổ biến của thiếu máu tan máu do bất thường màng hồng cầu.
Phân loại bệnh hồng cầu hình cầu di truyền
Dựa vào mức độ triệu chứng và mức độ thiếu máu, bệnh hồng cầu hình cầu thường được chia thành 3 mức độ chính.
- Thể nhẹ: Khoảng 20-30% người bệnh thuộc nhóm này. Người bệnh có thể chỉ bị thiếu máu tan máu nhẹ và hầu như không có triệu chứng rõ rệt cho đến khi bước vào độ tuổi 30 đến 40.
- Thể trung bình: Chiếm khoảng 60-75% tổng số ca bệnh. Nhóm này thường gặp ở trẻ sơ sinh và trẻ nhỏ, với các biểu hiện như thiếu máu tan máu mức độ nhẹ đến trung bình, vàng da, mệt mỏi
- Thể nặng: Chiếm khoảng 5% số người mắc bệnh hồng cầu hình cầu. Trẻ sơ sinh thuộc nhóm này thường xuất hiện thiếu máu nặng trong khoảng 1 tuần đầu sau sinh và cần được theo dõi, điều trị sớm.
 Phân loại bệnh hồng cầu hình cầu di truyền dựa trên mức độ thiếu máu
Phân loại bệnh hồng cầu hình cầu di truyền dựa trên mức độ thiếu máu
Nguyên nhân gây bệnh hồng cầu hình cầu
Nguyên nhân chính của bệnh hồng cầu hình cầu là do đột biến gen di truyền từ cha mẹ.
Các gen liên quan đến bệnh thường mã hóa protein cấu trúc của màng hồng cầu. Khi các gen này bị thay đổi, cấu trúc màng hồng cầu không còn ổn định, khiến tế bào dễ biến dạng và bị phá hủy.
Các kiểu di truyền phổ biến gồm
Di truyền trội trên nhiễm sắc thể thường
Khoảng 75% trường hợp bệnh hồng cầu hình cầu xảy ra theo kiểu di truyền này. Chỉ cần một bản sao gen đột biến từ cha hoặc mẹ là có thể gây bệnh.
Nếu cha hoặc mẹ mang gen bệnh, con có khoảng 50% nguy cơ mắc bệnh.
Di truyền lặn trên nhiễm sắc thể thường
Trong một số trường hợp hiếm hơn, trẻ nhận gen đột biến từ cả cha và mẹ. Cha mẹ thường chỉ mang gen bệnh nhưng không biểu hiện triệu chứng.
Khi cả hai cha mẹ đều mang gen bệnh:
- 25% khả năng con mắc bệnh
- 50% khả năng con mang gen bệnh nhưng không biểu hiện
- 25% khả năng con hoàn toàn bình thường
Vì sao đột biến gen làm thay đổi hình dạng hồng cầu?
Màng hồng cầu gồm lớp màng ngoài và hệ thống khung protein ở phía trong giúp duy trì hình dạng tế bào.
Nhờ cấu trúc này, hồng cầu có khả năng: uốn cong, xoắn lại, thay đổi hình dạng để di chuyển qua các mao mạch rất nhỏ và đi qua lách.
Ở người mắc bệnh hồng cầu hình cầu, các đột biến gen làm suy yếu liên kết giữa bộ khung protein và lớp màng tế bào. Khi liên kết này bị phá vỡ, màng hồng cầu mất tính ổn định, khiến tế bào chuyển từ dạng đĩa mềm dẻo sang dạng cầu cứng.
Những tế bào này khó di chuyển qua lách và thường bị giữ lại, dẫn đến hiện tượng phá hủy hồng cầu sớm.
 Đột biến gen khiến suy giảm liên kết gây màng hồng cầu mất tính ổn định
Đột biến gen khiến suy giảm liên kết gây màng hồng cầu mất tính ổn định
Đối tượng dễ mắc bệnh hồng cầu hình cầu
Theo thống kê, cứ khoảng 2000 đến 5000 người trên thế giới thì có 1 người mắc bệnh hồng cầu hình cầu. Bệnh thường được phát hiện ở trẻ sơ sinh, trẻ nhỏ, trẻ trong độ tuổi 3 đến 8
Tuy nhiên, một số trường hợp nhẹ có thể không xuất hiện triệu chứng rõ ràng cho đến khi trưởng thành, khoảng 30 đến 40 tuổi.
Trong một số trường hợp, trẻ sơ sinh có biểu hiện thiếu máu nặng trong tuần đầu sau sinh và cần được làm xét nghiệm máu để xác định bệnh.
Triệu chứng của bệnh hồng cầu hình cầu
Do hồng cầu bị phá hủy nhanh, người bệnh thường xuất hiện các biểu hiện thiếu máu tan máu.
Các triệu chứng phổ biến gồm
- Lách to: Lách có nhiệm vụ lọc và loại bỏ các tế bào hồng cầu bất thường. Ở người mắc bệnh hồng cầu hình cầu, lách giữ lại nhiều hồng cầu bất thường nên dần trở nên to hơn bình thường.
- Vàng da: Sự phá hủy hồng cầu làm tăng nồng độ bilirubin trong máu, dẫn đến vàng da, vàng mắt và vàng niêm mạc.
- Sỏi mật: Bilirubin tăng cao lâu dài có thể hình thành sỏi mật.
- Khó thở: Thiếu hồng cầu khiến cơ thể không được cung cấp đủ oxy, dẫn đến cảm giác khó thở.
- Mệt mỏi: Người bệnh thường xuyên mệt mỏi, giảm khả năng lao động và sinh hoạt.
- Nhịp tim nhanh: Tim phải hoạt động nhiều hơn để bù đắp lượng oxy thiếu hụt, dẫn đến nhịp tim tăng.
Bệnh hồng cầu hình cầu có nguy hiểm không?
Phần lớn người mắc bệnh hồng cầu hình cầu có tiên lượng khá tốt nếu được theo dõi và điều trị đúng cách.
Mức độ ảnh hưởng của bệnh phụ thuộc vào nhiều yếu tố như:
- Mức độ bệnh nhẹ, trung bình hay nặng
- Hiệu quả điều trị
- Tình trạng bệnh lý đi kèm
- Thể trạng chung của người bệnh
Chẩn đoán bệnh hồng cầu hình cầu
Để xác định bệnh hồng cầu hình cầu, bác sĩ sẽ kết hợp đánh giá triệu chứng lâm sàng, tiền sử gia đình và các xét nghiệm cận lâm sàng.
Các xét nghiệm thường được chỉ định gồm:
- Công thức máu toàn phần: Xét nghiệm này cung cấp thông tin về số lượng và đặc điểm của các tế bào máu.
- Phết máu ngoại vi: Giúp quan sát trực tiếp hình dạng hồng cầu dưới kính hiển vi.
- Đếm hồng cầu lưới: Đánh giá khả năng sản xuất hồng cầu của tủy xương.
- Xét nghiệm Coombs trực tiếp: Xét nghiệm kháng globulin trực tiếp giúp phân biệt thiếu máu tan máu do miễn dịch với các nguyên nhân khác.
- Định lượng bilirubin: Kiểm tra mức bilirubin trong máu.
- Kiểm tra độ giòn thẩm thấu của hồng cầu: Đánh giá khả năng vỡ của hồng cầu khi tiếp xúc với môi trường có áp lực thẩm thấu thay đổi.
- Điện di protein màng hồng cầu: Kỹ thuật điện di giúp xác định các protein màng hồng cầu bị bất thường hoặc thiếu hụt.
 Xét nghiệm máu giúp xác định đặc điểm của tế bào máu
Xét nghiệm máu giúp xác định đặc điểm của tế bào máu
Phương pháp điều trị bệnh hồng cầu hình cầu
Việc điều trị phụ thuộc vào độ tuổi, mức độ thiếu máu và triệu chứng của người bệnh.
Một số phương pháp điều trị thường được áp dụng gồm:
- Chiếu đèn điều trị vàng da: Áp dụng cho trẻ sơ sinh để làm giảm bilirubin trong máu.
- Truyền máu: Được chỉ định khi người bệnh bị thiếu máu nặng.
- Sử dụng thuốc kích thích tạo hồng cầu: Thuốc kích thích sinh hồng cầu giúp tủy xương tăng sản xuất hồng cầu.
- Phẫu thuật cắt lách: Đây là phương pháp điều trị hiệu quả đối với các trường hợp bệnh hồng cầu hình cầu nặng.
- Phẫu thuật cắt túi mật: Áp dụng khi người bệnh xuất hiện sỏi mật do bilirubin tăng cao.
- Liệu pháp thải sắt: Những bệnh nhân truyền máu nhiều lần có thể bị quá tải sắt. Liệu pháp thải sắt giúp loại bỏ lượng sắt dư thừa ra khỏi cơ thể.
Có thể phòng ngừa bệnh hồng cầu hình cầu không?
Do bệnh hồng cầu hình cầu có nguồn gốc di truyền, việc phòng ngừa hoàn toàn là rất khó.
Tuy nhiên, những người có tiền sử gia đình mắc bệnh nên thực hiện tư vấn di truyền, làm xét nghiệm sàng lọc khi cần thiết, theo dõi sức khỏe định kỳ. Bác sĩ sẽ dựa vào kết quả xét nghiệm để đánh giá nguy cơ mắc bệnh và hướng dẫn theo dõi phù hợp.
Bệnh hồng cầu hình cầu là một rối loạn di truyền ảnh hưởng đến cấu trúc và chức năng của hồng cầu, gây ra thiếu máu tan máu và nhiều biểu hiện lâm sàng khác. Việc phát hiện sớm và điều trị đúng cách giúp người bệnh kiểm soát tốt tình trạng bệnh và duy trì chất lượng cuộc sống.
Qua bài viết này của Bệnh viện Đa khoa Phương Đông, hy vọng đã cung cấp những thông tin hữu ích về bệnh hồng cầu hình cầu. Nếu Quý khách có bất kỳ thắc mắc nào có thể liên hệ BVĐK Phương Đông qua Hotline 1900 1806 hoặc để được nhân viên tư vấn và hỗ trợ nhanh chóng.